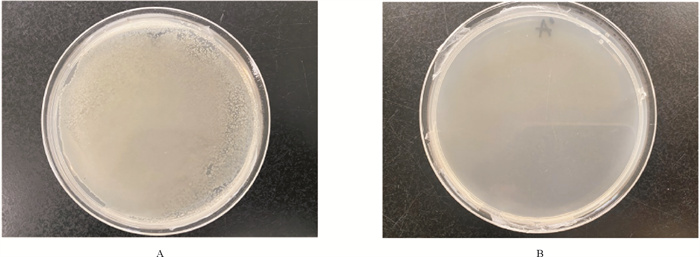

2. 青岛海洋科学与技术试点国家实验室 海洋渔业科学与食物产出过程功能实验室,山东 青岛 266237
自然环境或实验室条件下,微藻与细菌关系密切。在微藻生长过程中,有些细菌不仅能够促进藻类生长,诱导微藻活性物质的产生,还有助于絮凝[1-4],还有些细菌能产生鼠李糖脂或胞外丝氨酸蛋白酶,这些活性物质具有对赤潮藻类的杀藻作用[5-6]。因此,研究细菌对藻类生长及代谢的影响,对于优化藻类的培养技术及藻类产品的开发、应用具有重要意义,而进行微藻无菌化处理是获得微藻无菌培养物,开展微藻相关细菌功能研究的前提,也是实现微藻兼养、异养培养的基础。
因微藻种类及培养条件不同,微藻相关细菌组成也具有种间特异性。微藻无菌化方法既包括涡流、超声波处理[7-8]、密度梯度离心、连续稀释[9]和紫外线照射[10]等物理方法,也包括抗生素处理[11]、溶菌酶处理[12]及抗菌物质处理[13]等化学方法。而最常用的方法是抗生素法[4]。由于每种抗生素都有其特定的作用方式和靶细胞,因此了解微藻种类及其相关菌群结构,有助于选择合适的抗生素组合进行除菌,成功获得无菌藻株[14]。
隐秘小环藻(Cyclotella cryptica)作为一种广盐性海洋硅藻[15-16],其脂质含量可达总生物量的42%,其中TAG含量占总脂含量的55%左右[17],已被证明是一种良好的脂质生产者[18]。除了可进行传统的自养生长外,隐秘小环藻还能以葡萄糖为碳源进行异养生长[19-21]。与很多硅藻相似,隐秘小环藻也具有纳米级到微米级的多孔结构,具有良好的止血、药物缓释能力[22-24]。这显示出隐秘小环藻具有非常广阔的综合利用前景。
本研究探究了不同抗生素对隐秘小环藻藻液中细菌的抑制效果及对微藻生长的影响,同时对比分析了抗生素处理前后藻液细菌群落结构,进而设计了有效的抗生素组合进行隐秘小环藻的无菌化处理,为隐秘小环藻的培养方式优化以及藻际细菌功能研究奠定基础。
1 材料与方法 1.1 藻种来源及培养条件本研究的实验藻种——隐秘小环藻(Cyclotella cryptica)由中国海洋大学应用微藻生物学实验室种质库提供(编号LAMB 147)。微藻培养基采用f/2培养液,固体培养基追加1%的琼脂。海水经0.22 μm滤膜过滤,加入f/2母液,高温灭菌冷却后使用。原藻种长期保存于低温液体培养基中,先进行涂板挑取单藻落进行活化,再将活化后的藻种用于后续实验。培养温度为22 ℃,光照强度为40 μmol·m-2·s-1,光照周期(光∶暗)为12 h∶12 h。
1.2 实验试剂实验所用抗生素均购自北京索莱宝科技有限公司,实验开始前配制抗生素母液,其中硫酸庆大霉素、硫酸卡那霉素、硫酸新霉素、硫酸链霉素、氨苄青霉素、氯霉素母液浓度为50 mg·mL-1;盐酸环丙沙星母液浓度为25 mg·mL-1。抗生素母液经0.22 μm微孔过滤器过滤后,置于-20 ℃冷冻保存。实验所用细菌培养基为2216E固体培养基及2216E液体培养基,均购自海博生物有限公司。
1.3 除菌抗生素种类及浓度的确定 1.3.1 藻液中细菌对不同抗生素的敏感性选取硫酸庆大霉素、硫酸卡那霉素、硫酸新霉素、硫酸链霉素、氨苄青霉素、氯霉素6种抗生素。将母液进行稀释,使各抗生素终浓度为200、400、600和800 μg·mL-1,将直径为6 mm的滤纸片浸泡在相应浓度的抗生素中,置于37 ℃恒温培养箱烘干备用。取100 μL处于指数生长期的藻液,稀释后涂布于2216E固体培养基,分别将含有不同浓度抗生素的滤纸片平贴在培养基上,各浓度抗生素做3个平行。置于37 ℃恒温培养箱倒置培养48 h,观察并测量抑菌圈大小。选择对藻液中细菌抑制作用强的抗生素作为除菌工具。
1.3.2 藻细胞对不同抗生素的耐受性比较取适量处于指数生长期的藻液接种于120 mL新鲜灭菌f/2培养基中,初始OD750为0.050。分别向培养基中添加上述6种抗生素,使其终浓度分别为200、400、600和800 μg·mL-1,并以不添加抗生素(0 μg·mL-1)作为对照,实验组和对照组分别设置3个平行。培养方式同1.1,连续培养7 d,每天定点摇藻,并随机变换位置。每隔48 h取1 mL藻液,利用血球计数板进行计数测定细胞密度。后续补充实验中盐酸环丙沙星的作用终浓度分别为25、50、75和100 μg·mL-1,处理方式同上。根据不同抗生素对隐秘小环藻生长的影响,选择对微藻毒害作用小的抗生素种类及浓度用于后续除菌。
1.4 单一抗生素除菌后藻液细菌多样性及群落结构分析取适量处于指数生长期的藻液接种于120 mL新鲜灭菌f/2培养基,分别使用800 μg·mL-1氨苄青霉素、800 μg·mL-1硫酸卡那霉素、800 μg·mL-1硫酸链霉素以及600 μg·mL-1的硫酸新霉素和600 μg·mL-1硫酸庆大霉素处理3 d,以不加抗生素的藻液作为对照组,实验组和对照组分别设置3个平行。处理结束后各取藻液50 mL,用0.22 μm的滤膜过滤,富集黏附细菌及游离细菌。将各处理组的3个平行混合作为一个样品,并分别对样品进行编号。将样品送至联川生物有限公司进行16S rRNA基因高通量测序,比较抗生素处理及未处理隐秘小环藻藻液细菌多样性及群落结构变化。
采用CTAB法提取样品总DNA,使用琼脂糖凝胶电泳检测总DNA提取质量,并使用紫外分光光度计检测总DNA的浓度和纯度。以样品DNA为模板,选择细菌16S rRNA基因V3~V4区引物序列341F(5’-CCTACGGGNGGCWGCAG-3’)和805R(5’-GACTACHVGGGTATCTAATCC-3’), 进行PCR扩增,扩增产物经2%琼脂糖凝胶电泳检测,并用AMPure XT beads纯化试剂盒进行纯化。将纯化的扩增产物进行文库构建,检测合格后,使用Illumina NovaSeq高通量测序平台进行双端测序。
首先将测序获得的原始序列使用cutadapt软件去除引物序列和平衡碱基序列;使用FLASH软件将每对Pair-end reads进行拼接;使用fqtrim软件进行过滤质控,去除低质量序列;使用Vsearch软件去除嵌合体序列;使用Qiime2软件去噪,获得ASV(Feature)特征序列和ASV(Feature)丰度表。利用Qiime 2软件计算样品Alpha多样性指数,包括Observed OTUs、Shannon、Simpson和Chao1。根据获得的ASV(Feature)特征序列,使用SILVA数据库(Release 138)以及NT-16S数据库进行物种注释,并根据ASV(Feature)丰度表对各物种在各样本中丰度进行统计。
1.5 抗生素组合除菌首先,使用600 μg·mL-1硫酸庆大霉素、800 μg·mL-1硫酸卡那霉素、800 μg·mL-1硫酸链霉素抗生素组合进行除菌。但这一组合处理后仍残留少量细菌,在对残留细菌进行分离鉴定基础上,追加对残留细菌有明显抑制作用的盐酸环丙沙星进行有针对性的除菌处理。
随后,采用2种组合方式进行除菌。组合一:将处于指数生长期的藻液接种于新鲜无菌培养基,同时添加600 μg·mL-1硫酸庆大霉素、800 μg·mL-1硫酸卡那霉素、800 μg·mL-1硫酸链霉素和25 μg·mL-1盐酸环丙沙星联合处理3 d。组合二:将处于指数生长期的藻液接种于新鲜无菌培养基,先添加600 μg·mL-1硫酸庆大霉素、800 μg·mL-1硫酸卡那霉素、800 μg·mL-1硫酸链霉素联合处理3 d,离心洗涤后重新接种于新鲜灭菌培养基,培养3 d后,再次离心洗涤,接种于新鲜培养基,追加25 μg·mL-1的盐酸环丙沙星处理3 d。
1.6 无菌效果检验在每种抗生素组合处理结束时进行无菌检验。另外,将除菌后微藻转入不含抗生素的无菌培养基中传代培养3次后(各代培养7 d)再次进行无菌检验。检验方式为平板培养法和荧光染色观察法[11]。其中平板培养法中一种方式是取藻液100 μL涂布于2216E固体培养基,培养数天后观察有无菌落出现;另一种方式是取适量藻液接种于改进f/2液体培养基,即在原f/2培养基基础上添加5 g·L-1蛋白胨和1 g·L-1酵母膏,置于适宜条件下培养5 d后,再次进行涂板检验,观察有无菌落出现。荧光染色观察法是取100 μL藻液,加入0.1 μL SYBR Green Ⅰ进行染色,观察染色情况。两种方法均以未经抗生素处理的藻细胞作对照。
1.7 带菌藻株和无菌藻株的生长比较无菌隐秘小环藻在不含抗生素的f/2培养基中传代培养5次(各代培养7 d)后用于生长比较实验。将处于指数生长期的无菌和带菌隐秘小环藻按1.833×105 cells·mL-1的初始密度分别接种于120 mL新鲜f/2培养基,每组设置3个平行。培养条件下同1.1,培养周期为8 d,每天定点取1 mL藻液,采用血球计数板法计数藻细胞密度。
1.8 统计分析本研究将3组平行的实验数据均用于结果分析,计算平均值及标准差,用Origin软件进行数据整理并作图,采用SPSS软件对数据进行单因素方差分析(ANOVA),显著性水平为p < 0.05。
2 结果 2.1 除菌抗生素种类及浓度 2.1.1 不同抗生素对藻液中细菌的抑制效果以抑菌圈大于20 mm作为抗生素具有显著抑菌效果的判断标准,由表 1可以看出,4个实验浓度的氨苄青霉素、浓度不小于400 μg·mL-1的氯霉素以及浓度为800 μg·mL-1的硫酸庆大霉素抑菌效果均十分显著,而浓度低于800 μg·mL-1的硫酸链霉素和硫酸卡那霉素及浓度为200 μg·mL-1的硫酸新霉素抑菌效果均较差。
|
|
表 1 不同种类及浓度抗生素对隐秘小环藻藻液中细菌的抑制效果 Table 1 The inhibitory effects of different types and concentrations of antibiotics on bacteria in algae liquid of Cyclotella cryptica |
不同浓度的硫酸庆大霉素、硫酸新霉素、硫酸卡链霉素及硫酸卡那霉素均能促进隐秘小环藻生长(见图 1 A~D)。其中600 μg·mL-1的硫酸庆大霉素和硫酸新霉素以及800 μg·mL-1硫酸链霉素和硫酸卡那霉素对隐秘小环藻的生长促进作用最明显,培养至第7天时,藻细胞密度约为对照组的1.4~1.6倍。各浓度的氨苄青霉素对隐秘小环藻均无抑制作用,各处理组与对照组的藻细胞密度无显著差异(p>0.05)(见图 1 E)。隐秘小环藻对氯霉素极其敏感,当浓度为200 μg·mL-1时,就能显著抑制其生长,随着浓度升高,抑制程度也增强,培养至第5天时,藻液变白,藻细胞死亡(见图 1F)。

|
( A:硫酸庆大霉素Gentamicin sulfate;B:硫酸新霉素Neomycin sulfate;C:硫酸链霉素Streptomycin sulfate;D:硫酸卡那霉素Kanamycin sulphate;E:氨苄青霉素Ampicillin;F:氯霉素Chloramphenicol;G:盐酸环丙沙星Ciprofloxacin hydrochloride. ) 图 1 不同抗生素处理对隐秘小环藻生长的影响 Fig. 1 Effects of different antibiotics treatment on the growth of Cyclotella cryptica |
隐秘小环藻对盐酸环丙沙星的耐受性实验结果显示(见图 1 G),在实验浓度范围内,随着浓度升高、时间延长,盐酸环丙沙星对隐秘小环藻的抑制效果越来越显著。培养至第3天时,浓度为25 μg·mL-1的盐酸环丙沙星处理组,藻细胞密度为4.175×105 cells·mL-1,比对照组降低了3.8%左右,培养至第7天时,藻细胞密度比对照组降低了16.4%左右。综合考虑,在用盐酸环丙沙星除菌时,建议使用浓度25 μg·mL-1的盐酸环丙沙星处理3 d。
2.2 单一抗生素除菌后藻液细菌多样性及群落结构根据上述实验结果,最终确定分别使用600 μg·mL-1硫酸庆大霉素、600 μg·mL-1硫酸新霉素、800 μg·mL-1硫酸链霉素、800 μg·mL-1硫酸卡那霉素和800 μg·mL-1氨苄青霉素进行除菌。抗生素处理前后藻液细菌多样性指数比较结果显示(见表 2),与未经抗生素处理相比,各抗生素处理后各项指数均下降,这说明抗生素处理后藻液中细菌多样性和细菌丰富度均降低。
|
|
表 2 单一抗生素处理前后隐秘小环藻藻液中细菌群落α-多样性指数 Table 2 Alpha diversity index of the bacteria communities in algae liquid of Cyclotella cryptica before and after single antibiotic treatment |
具体分析各处理组的细菌群落结构,结果显示不同抗生素处理的细菌群落组成明显不同。对照组中隐秘小环藻的优势菌门为Proteobacteria(变形菌门)、Planctomycetes(浮霉菌门)和Bacteroidetes(拟杆菌门),其相对丰度分别为43.87%、30.22%和25.40%(见图 2 A)。抗生素处理后,各处理组优势菌门均为Cyanobacteria(蓝细菌门),其丰度由原来的0.21%增加至66.02%~87.08%,变形菌门细菌相对丰度在5.90%~20.29%之间;浮霉菌门细菌相对丰度在0.95%~5.80%之间;拟杆菌门细菌相对丰度在4.05%~8.27%之间。原优势菌群相对丰度均显著降低。

|
( Con: 对照组Control;CN:硫酸庆大霉素处理组Gentamicin sulfate treated group;K:硫酸卡那霉素处理组Kanamycin sulphate treated group;N:硫酸新霉素处理组Neomycin sulfate treated group;S:硫酸链霉素处理组Streptomycin sulfate treated group;AMP:氨苄青霉素处理组Ampicillin treated group。) 图 2 单一抗生素处理前后隐秘小环藻藻液中门水平(A)和属水平(B)的细菌群落结构 Fig. 2 Bacteria community composition at phylum level and genus level in algae liquid of Cyclotella cryptica before and after single antibiotic treatment |
具体到属水平上(见图 2 B),对照组中Roseimaritima(玫瑰菌属)、Marinibacterium(海杆菌属)、Muricauda(鼠尾菌属)、Halomonas(盐单胞菌属)和Alii-diomarina是隐秘小环藻藻液中5个优势菌属,占总细菌的97%以上。而在抗生素处理后,蓝细菌门的Oxyphotobacteria_unclassified则成为占比最高的细菌属,丰度最低的氨苄青霉素处理组为66.02%,最高的硫酸链霉素处理组为87.08%。抗生素处理后Aliidio-marina相对丰度也显著增加,以氨苄青霉素处理组的变化最为显著,由对照组的1.33%增加至13.40%。而Marinibacterium、Roseimaritima、Muricauda、Halomonas四个原有的优势属在抗生素处理后相对丰度均降低。氨苄青霉素处理组Marinibacterium相对丰度仅为0.22%,显著低于其他处理组。硫酸卡那霉素处理组和硫酸庆大霉素处理组中Roseimaritima相对丰度最低,分别由对照组的30.20%降低至0.95%和0.99%。硫酸链霉素处理组和硫酸卡那霉素处理组中的Muricauda相对丰度分别为4%和4.34%,也显著低于其他处理组。氨苄青霉素处理组中的Halomonas相对丰度为5.82%,其他处理组该属细菌的相对丰度在0.6%~0.7%,均显著低于对照组。结果表明,不同抗生素抑菌能力存在明显的种属差异性。
2.3 抗生素组合的除菌效果及分析根据单一抗生素处理前后藻液细菌多样性及菌群结构变化情况,选择对隐秘小环藻藻液中优势菌抑菌作用最显著的硫酸庆大霉素(600 μg·mL-1)、硫酸卡那霉素(800 μg·mL-1)和硫酸链霉素(800 μg·mL-1)组合进行除菌。3种抗生素组合处理后,涂板检验仍存在少量细菌,经鉴定均为拟杆菌门的Muricauda sp.。针对Muricauda sp.,又追加对该菌具有显著抑制作用的盐酸环丙沙星来进行处理。
首先,同时添加4种抗生素除菌后,经涂板检验,平板上未出现细菌。SYBR Green Ⅰ染色结果显示无细菌。但除菌后的隐秘小环藻无法传代培养,接种到新鲜无菌培养基后藻液变白,藻细胞死亡。说明这一组合除菌方式对藻细胞的抑制作用强,不适用于隐秘小环藻的无菌化处理。
随后,采用先添加3种抗生素除菌,离心洗涤除去抗生素,重新接种到新鲜培养基,再添加盐酸环丙沙星除菌,经涂板检验无细菌生长,而未处理的对照组平板上出现大量细菌(见图 3)。SYBR Green Ⅰ染色20 min,在荧光显微镜下未观察到被染色的细菌。除菌后的隐秘小环藻多次传代培养后也未观察到细菌(见图 4)。这表明该抗生素组合除菌方式用于隐秘小环藻的无菌化处理是可行的。
|
( A:未经抗生素处理的隐秘小环藻Cyclotella cryptica without antibiotics treatment;B:经抗生素处理的隐秘小环藻B:Cyclotella cryptica treated with antibiotics。) 图 3 抗生素处理前后2216E平板培养效果 Fig. 3 The effect of axenic treatment checked by 2216E solid medium |

|
( A:未经抗生素处理的隐秘小环藻Cyclotella cryptica without antibiotics treatment;B:为经抗生素处理的隐秘小环藻Cyclotella cryptica treated with antibiotics。图A和B中,藻细胞是红色的,微藻的细胞核是黄色的,细菌是绿色的。白色箭头指向细菌。In A and B algae cells are red, microalgae nuclei are yellow, and bacteria are green. White arrows point to bacteria. ) 图 4 抗生素处理前后SYBR Green Ⅰ染色效果(400×) Fig. 4 Effect of SYBR Green I staining before and after antibiotic treatment(400×) |
连续培养初始细胞密度相同的带菌藻株和无菌藻株8 d,与带菌藻株相比,无菌隐秘小环藻培养液中藻细胞悬浮性较好,而带菌藻株培养液中藻细胞容易沉底。2种培养液的藻细胞密度均呈现相似的增长趋势(见图 5),但无菌藻株细胞密度总是低于带菌藻株,培养至第8天,带菌藻株的细胞密度为1.117×106 cells·mL-1,无菌藻株的细胞密度为9.333×105 cells·mL-1,无菌藻株比带菌藻株的生长量低16.4%左右。

|
图 5 带菌藻株和无菌藻株生长比较 Fig. 5 Comparison of the growth of xenic Cyclotella cryptica and axenic Cyclotella cryptica |
抗生素法作为一种常用的除菌方式被广泛应用于实验室条件下微藻的无菌化处理,利用抗生素除菌的关键是选择对微藻毒害作用小且能有效除菌的抗生素。本研究比较了6种常用抗生素对隐秘小环藻生长的影响以及对藻液中细菌的抑制效果,发现氯霉素严重抑制隐秘小环藻的生长,除氯霉素和氨苄青霉素外,其他抗生素均能促进隐秘小环藻生长。在实验浓度范围内,藻液中细菌对浓度为600~800 μg·mL-1的抗生素敏感。Cao等[25]研究表明,抗生素的添加对微藻生长的促进作用与微藻培养液中有害菌被抑制有关,且500 μg·mL-1氨苄青霉素能够改善球等鞭金藻的光合活性,从而促进其生长。在Zhong等[26]的研究中,高浓度抗生素会降低藻细胞的叶绿素a含量,同时使藻细胞中活性氧水平快速增加,这是导致微藻生长受到抑制的重要原因。某些抗生素对微藻的影响还具有双重性,例如,高浓度(5~100 μg·L-1)的阿奇霉素会削弱蛋白核小球藻的光合活性,造成氧化损伤,抑制生长,而低浓度时(0.5和1 μg·L-1)反而会刺激小球藻生长[27]。青霉素在500 μg·mL-1时会抑制普通小球藻和蛋白核小球藻生长[28],而本研究中800 μg·mL-1的氨苄青霉素对隐秘小环藻无影响。由此可见,除菌抗生素种类及浓度与微藻种类密切相关。
本研究根据微藻对不同抗生素的耐受性实验以及药敏实验,确定了除菌抗生素种类及作用浓度,并对抗生素处理前后藻液细菌多样性及群落结构进行对比分析,发现与未经抗生素处理相比,抗生素处理后藻液中细菌OTU数量大幅减少且细菌多样性降低,且不同抗生素对隐秘小环藻藻液中细菌的抑制效果存在种属的特异性。如硫酸链霉素能降低隐秘小环藻中拟杆菌门细菌Muricauda的相对丰度,硫酸卡那霉素对浮霉菌门细菌Roseimaritima的抑制作用最强,硫酸庆大霉素能抑制大部分变形菌门细菌,如Marinibacterium、Halomonas、Aliidiomarina。以上3种抗生素对隐秘小环藻的优势菌具有很好的抑制效果。
在微藻无菌化过程中,抗生素组合除菌通常比单种抗生素除菌效果更佳。Su等[29]采用了庆大霉素、链霉素、头孢菌素(各100 μg·mL-1)和利福平(10 μg·mL-1)的抗生素组合进行除菌,成功获得了塔玛亚历山大藻的无菌培养物。本研究首先选择硫酸庆大霉素(600 μg·mL-1)、硫酸卡那霉素(800 μg·mL-1)和硫酸链霉素(800 μg·mL-1)的抗生素组合用于隐秘小环藻的无菌化处理。结果发现无论采用单种抗生素逐一添加还是3种抗生素同时添加的方式,无菌检验后总有Muricauda属细菌存在。鉴于该属细菌对环丙沙星敏感[30],故后续除菌时追加25 μg·mL-1盐酸环丙沙星。但是同时添加4种抗生素除菌并未获得无菌藻株,实验过程中藻细胞逐渐变白直至死亡。考虑到同时添加4种抗生素对藻细胞造成了严重损伤,本研究首先用600 μg·mL-1硫酸庆大霉素、800 μg·mL-1硫酸卡那霉素和800 μg·mL-1硫酸链霉素的抗生素组合除菌后,收集藻细胞并用无菌水冲洗数次,以消除存留的抗生素,再追加盐酸环丙沙星除菌,最终获得了隐秘小环藻的无菌藻株。以上结果说明,在使用抗生素进行微藻的无菌化处理时,抗生素的添加方式也是成功获得无菌藻株的重要因素。
除菌后的隐秘小环藻进行多次传代培养,排除抗生素的影响,比较其生长情况,结果显示与带菌藻株相比,无菌藻株的生长速率较低,培养8 d的细胞密度要显著低于未除菌对照组。这与Scholz等[8]研究结果一致,未除菌的Navicula palpebralis生长速度比无菌藻株高29%。这表明抗生素处理在除去抑制藻类生长细菌的同时可能也杀死了部分能够促进藻类生长的有益菌。这些有益菌通过分泌植物激素或将有机营养物矿化为无机物的方式促进藻类生长[31-32]。关于隐秘小环藻相关细菌对微藻生长的影响还需通过菌藻共培养进行深入研究。
| [1] |
Ramanan R, Kim B H, Cho D H, et al. Algae-bacteria interactions: Evolution, ecology and emerging applications[J]. Biotechnology Advances, 2015, 34(1): 14-29. (  0) 0) |
| [2] |
Fuentes J L, Garbayo I, Cuaresma M, et al. Impact of microalgae-bacteria interactions on the production of algal biomass and associated compounds[J]. Marine Drugs, 2016, 14(5): 100. DOI:10.3390/md14050100 (  0) 0) |
| [3] |
Han J C, Zhang L, Wang S, et al. Co-culturing bacteria and microalgae in organic carbon containing medium[J]. Journal of Biological Research-Thessaloniki, 2016, 23(1): 8. DOI:10.1186/s40709-016-0047-6 (  0) 0) |
| [4] |
Vu C H T, Lee H G, Chang Y K, et al. Axenic cultures for microalgal biotechnology: Establishment, assessment, maintenance, and applications[J]. Biotechnology Advances, 2018, 36(2): 380-396. DOI:10.1016/j.biotechadv.2017.12.018 (  0) 0) |
| [5] |
Lee S O, Kato J, Takiguchi N, et al. Involvement of an extracellular protease in algicidal activity of the marine bacterium Pseudoa-lteromonas sp. strain A28[J]. Applied and Environmental Microbiology, 2000, 66(10): 4334-4339. DOI:10.1128/AEM.66.10.4334-4339.2000 (  0) 0) |
| [6] |
Wang X L, Gong L Y, Liang S K, et al. Algicidal activity of rhamnolipid biosurfactants produced by Pseudomonas aeruginosa[J]. Harmful Algae, 2005, 4(2): 433-443. DOI:10.1016/j.hal.2004.06.001 (  0) 0) |
| [7] |
Bruckner C G, Kroth P G. Protocols for the removal of bacteria from freshwater benthic diatom cultures[J]. Journal of Phycology, 2009, 45(4): 981-986. DOI:10.1111/j.1529-8817.2009.00708.x (  0) 0) |
| [8] |
Scholz B, Bowler C. Purification and culture characteristics of 36 benthic marine diatoms isolated from the Solthrn tidal flat (Southern North Sea)[J]. Journal of Phycology, 2014, 50(4): 685-697. DOI:10.1111/jpy.12193 (  0) 0) |
| [9] |
Lee T C H, Chan P L, Tam N F Y, et al. Establish axenic cultures of armored and unarmored marine dinoflagellate species using density separation, antibacterial treatments and stepwise dilution selection[J]. Scientific Reports, 2021, 11(1): 202. DOI:10.1038/s41598-020-80638-x (  0) 0) |
| [10] |
Sulcius S, Slavuckyte K, Januskaite M, et al. Establishment of axenic cultures from cyanobacterium Aphanizomenon flos-aquae akinetes by micromanipulation and chemical treatment[J]. Algal Research, 2017, 23: 43-50. DOI:10.1016/j.algal.2017.01.006 (  0) 0) |
| [11] |
Han J C, Wang S, Zhang L, et al. A method of batch-purifying microalgae with multiple antibiotics at extremely high concentrations[J]. Chinese Journal of Oceanology and Limnology, 2016, 34(1): 79-85. DOI:10.1007/s00343-015-4288-2 (  0) 0) |
| [12] |
Kim J, Park Y, Yoon B, et al. Note establishment of axenic cultures of Anabaena flos-aquae and Aphanothece nidulans (cyanobacteria) by lysozyme treatment[J]. Journal of Phycology, 1999, 35(4): 865-869. DOI:10.1046/j.1529-8817.1999.3540865.x (  0) 0) |
| [13] |
Nam K, Shin W S, Jeong B R, et al. Use of a triiodide resin for isolation of axenic cultures of microalgal Nannochloropsis gaditana[J]. Bioresource Technology, 2015, 191: 391-394. DOI:10.1016/j.biortech.2015.03.082 (  0) 0) |
| [14] |
Choi G G, Bae M S, Ahn C Y, et al. Induction of axenic culture of Arthrospira (Spirulina) platensis based on antibiotic sensitivity of contaminating bacteria[J]. Biotechnology Letters, 2008, 30(1): 87-92. (  0) 0) |
| [15] |
Liu M S, Hellebust J A. Effects of salinity changes on growth and metabolism of the marine centric diatom Cyclotella cryptica[J]. Canadian Journal of Botany, 1976, 54(9): 930-937. DOI:10.1139/b76-097 (  0) 0) |
| [16] |
Pahl S L, Lewis D M, Chen F, et al. Heterotrophic growth and nutritional aspects of the diatom Cyclotella cryptica (Bacillariophyceae): Effect of some environmental factors[J]. Journal of Bioscience and Bioengineering, 2010, 109(3): 235-239. DOI:10.1016/j.jbiosc.2009.08.480 (  0) 0) |
| [17] |
d'Ippolito G, Sardo A, Paris D, et al. Potential of lipid metabolism in marine diatoms for biofuel production[J]. Biotechnology for Biofuels and Bioproducts, 2015, 8(1): 28. DOI:10.1186/s13068-015-0212-4 (  0) 0) |
| [18] |
Slocombe S P, Zhang Q Y, Ross M, et al. Unlocking nature's treasure-chest: Screening for oleaginous algae[J]. Scientific Reports, 2015, 5(1): 9844. DOI:10.1038/srep09844 (  0) 0) |
| [19] |
Hellebust J A. Kinetics of glucose transport and growth of Cyclotella cryptica Reimann, Lewin and Guillard[J]. Journal of Phycology, 1971, 7(1): 1-4. (  0) 0) |
| [20] |
Alan W, White. Growth of two facultatively heterotrophic marine centric diatoms[J]. Journal of Phycology, 1974, 10: 292-300. (  0) 0) |
| [21] |
Hellebust J A. Glucose uptake by Cyclotella cryptica: Dark induction and light inactivation of transport system[J]. Journal of Phycology, 1971, 7(4): 345-349. (  0) 0) |
| [22] |
Gordon R, Losic D, Tiffany M A, et al. The glass menagerie: Diatoms for novel applications in nanotechnology[J]. Trends in Biotechnology, 2009, 27(2): 116-127. DOI:10.1016/j.tibtech.2008.11.003 (  0) 0) |
| [23] |
Wang L L, Pan K H, Li J, et al. Influence of the physicochemical characteristics of diatom frustules on hemorrhage control[J]. Biomaterials Science, 2019, 7(5): 1833-1841. (  0) 0) |
| [24] |
Zhang K C, Li J, Wang Y N, et al. Hydroxybutyl chitosan/diatom-biosilica composite sponge for hemorrhage control[J]. Carbohydrate Polymers, 2020, 236: 116051. DOI:10.1016/j.carbpol.2020.116051 (  0) 0) |
| [25] |
Cao J Y, Kong Z Y, Zhang Y F, et al. Bacterial community diversity and screening of growth-affecting bacteria from Isochrysis galbana following antibiotic treatment[J]. Frontiers in Microbio-logy, 2019, 10: 994. (  0) 0) |
| [26] |
Zhong X Q, Zhu Y L, Wang Y J, et al. Effects of three antibio-tics on growth and antioxidant response of Chlorella pyrenoidosa and Anabaena cylindrica[J]. Ecotoxicology and Environmental Safety, 2021, 211: 111954. DOI:10.1016/j.ecoenv.2021.111954 (  0) 0) |
| [27] |
Mao Y F, Yu Y, Ma Z X, et al. Azithromycin induces dual effects on microalgae: Roles of photosynthetic damage and oxidative stress[J]. Ecotoxicology and Environmental Safety, 2021, 222: 112496. (  0) 0) |
| [28] |
王海英, 裴国凤, 杨柳. 2株污染小球藻的除菌技术[J]. 水生态学杂志, 2010, 31(4): 146-149. Wang H Y, Pei G F, Yang L. Preliminary study on purification of two microbial contaminated strains of Chlorella[J]. Journal of Hydroecology, 2010, 31(4): 146-149. (  0) 0) |
| [29] |
Su J Q, Yang X R, Zheng T L, et al. An efficient method to obtain axenic cultures of Alexandrium tamarense—a PSP-producing dinoflagellate[J]. Journal of Microbiological Methods, 2007, 69(3): 425-430. (  0) 0) |
| [30] |
刘施琪. 南海冷泉微生物多样性分析及一株新菌的鉴定[D]. 北京: 中国科学院大学, 2019. Liu S Q. A Study of the Microbial Diversity in the Cold Seep of South China Sea and Description of a Novel Bacterial Species[D]. Beijing: Chinese Master's Theses, 2019. (  0) 0) |
| [31] |
Dao G H, Wu G X, Wang X X, et al. Enhanced microalgae growth through stimulated secretion of indole acetic acid by symbiotic bacteria[J]. Algal Research, 2018, 33: 345-351. (  0) 0) |
| [32] |
Yao S, Lyu S, An Y, et al. Microalgae-bacteria symbiosis in microalgal growth and biofuel production: A review[J]. Journal of Applied Microbiology, 2019, 126(2): 359-368. (  0) 0) |
2. Laboratory for Marine Fisheries Science and Food Production Processes, Pilot National Laboratory for Marine Science and Technology(Qingdao), Qingdao 266237, China
 2022, Vol. 52
2022, Vol. 52


